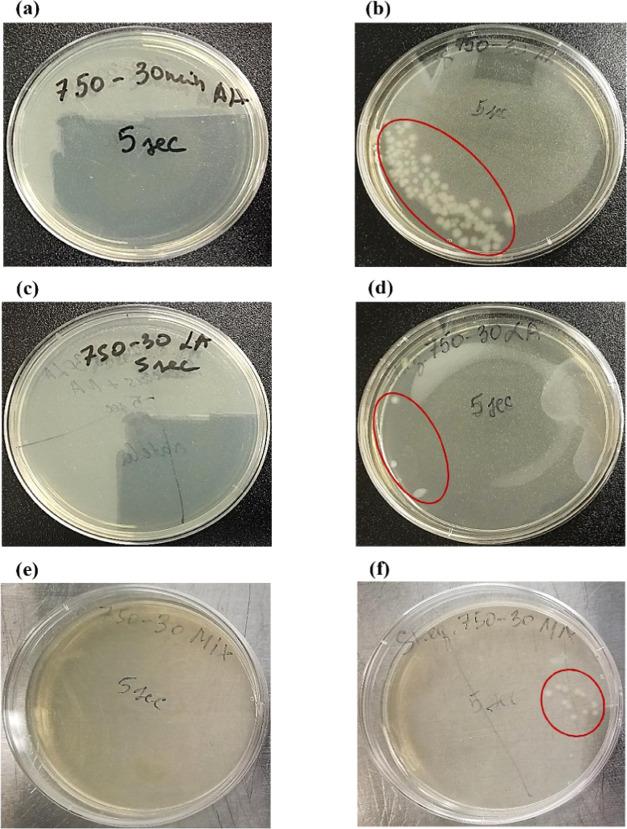
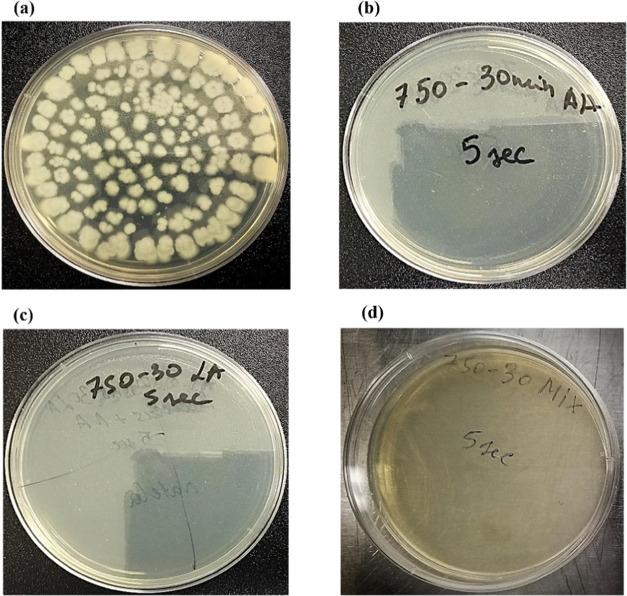

乳酸钙和抗坏血酸钙电激活溶液对ATCC 14579营养细胞抗菌效力的研究
Study of the Antibacterial Potency of Electroactivated Solutions of Calcium Lactate and Calcium Ascorbate on ATCC 14579 Vegetative Cells.
作者信息
Cayemitte Pierre Emerson, Gerliani Natela, Raymond Philippe, Aider Mohammed
机构信息
Department of Food Sciences, Université Laval, Quebec, Quebec G1V0A6, Canada.
Institute of Nutrition and Functional Foods (INAF), Université Laval, Quebec, Quebec G1V0A6, Canada.
出版信息
ACS Omega. 2022 Jan 21;7(4):3579-3595. doi: 10.1021/acsomega.1c06124. eCollection 2022 Feb 1.
is a pathogenic bacterium, Gram-positive, aerobic, and facultative anaerobic that can produce spores and different toxins. It is involved in serious foodborne illnesses such as the diarrheal and emetic syndromes, depending on the ingested toxin. This work is aimed to study the potency of electroactivated solutions (EAS) of calcium lactate, calcium ascorbate, and their mixture as antibacterial agents against ATCC 14579 vegetative cells. The solutions used were electroactivated under electric current intensities of 250, 500, and 750 mA for 30 min. The obtained EAS were tested in direct contact with (10 CFU/mL) for different durations ranging from 5 s to 2 min. Moreover, standard lactic and ascorbic acids were tested as controls at equivalent titratable acidity as that of the corresponding electroactivated solutions. The obtained results showed that EAS exhibit high antibacterial efficacy against vegetative cells. The EAS obtained after electroactivation of calcium lactate and calcium ascorbate were more efficient than those of their corresponding standard acids (lactic and ascorbic). The observed antibacterial effect of the EAS resulted in a reduction of 7 log CFU/mL after 5 s of direct contact in some specific cases. Scanning (SEM) and transmission (TEM) electron microscopic observations provided conclusive evidence of the antibacterial activity of the used EAS. These results outlined the highly antimicrobial potency of EAS against vegetative cells and that they can be considered in an eventual strategy to ensure food safety, surface cleaning, as well as replacement of hazardous disinfecting chemicals.
是一种革兰氏阳性、需氧兼性厌氧的致病细菌,可产生孢子和不同毒素。它会引发严重的食源性疾病,如腹泻和呕吐综合征,具体取决于摄入的毒素。这项工作旨在研究乳酸钙、抗坏血酸钙及其混合物的电激活溶液(EAS)作为针对ATCC 14579营养细胞的抗菌剂的效力。所使用的溶液在250、500和750 mA的电流强度下进行30分钟的电激活。将获得的EAS与(10 CFU/mL)直接接触进行不同时长(从5秒到2分钟)的测试。此外,以与相应电激活溶液相当的可滴定酸度测试标准乳酸和抗坏血酸作为对照。所得结果表明,EAS对营养细胞具有高抗菌效力。乳酸钙和抗坏血酸钙电激活后获得的EAS比其相应的标准酸(乳酸和抗坏血酸)更有效。在某些特定情况下,EAS直接接触5秒后观察到的抗菌效果导致细菌减少7 log CFU/mL。扫描电子显微镜(SEM)和透射电子显微镜(TEM)观察为所用EAS的抗菌活性提供了确凿证据。这些结果概述了EAS对营养细胞的高度抗菌效力,并且在确保食品安全、表面清洁以及替代有害消毒化学品的最终策略中可以考虑使用它们。